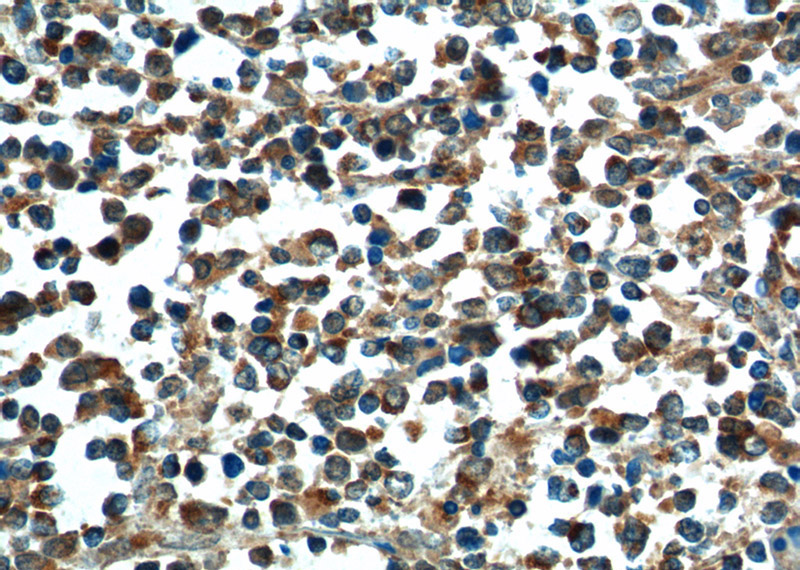
Immunohistochemistry of paraffin-embedded human lymphoma tissue slide using Catalog No:108364(BAX Antibody) at dilution of 1:200 (under 40x lens).

-
Product Name
BAX antibody
- Documents
-
Description
BAX Rabbit Polyclonal antibody. Positive IP detected in Raji cells. Positive WB detected in HeLa cells, COLO 320 cells, HEK-293 cells, mouse kidney tissue, Raji cells, rat kidney tissue, RAW264.7 cells. Positive FC detected in Raji cells, HeLa cells. Positive IHC detected in human lymphoma tissue, human gliomas tissue, human testis tissue, mouse brain tissue. Positive IF detected in HEK-293 cells, HeLa cells. Observed molecular weight by Western-blot: 21-24 kDa
-
Tested applications
ELISA, WB, IP, IF, IHC, FC
-
Species reactivity
Human, Mouse, Rat; other species not tested.
-
Alternative names
Apoptosis regulator BAX antibody; BAX antibody
-
Isotype
Rabbit IgG
-
Preparation
This antibody was obtained by immunization of BAX recombinant protein (Accession Number: NM_138761). Purification method: Protein A purified.
-
Clonality
Polyclonal
-
Formulation
PBS with 0.1% sodium azide and 50% glycerol pH 7.3.
-
Storage instructions
Store at -20℃. DO NOT ALIQUOT
-
Applications
Recommended Dilution:
WB: 1:1000-1:10000
IP: 1:1000-1:10000
IHC: 1:20-1:200
IF: 1:10-1:100
-
Validations

HeLa cells were subjected to SDS PAGE followed by western blot with Catalog No:108364(BAX antibody) at dilution of 1:2000

IP Result of anti-BAX (IP:Catalog No:108364, 3ug; Detection:Catalog No:108364 1:2000) with Raji cells lysate 3500ug.

Immunohistochemistry of paraffin-embedded human lymphoma tissue slide using Catalog No:108364(BAX Antibody) at dilution of 1:200 (under 10x lens).
Immunohistochemistry of paraffin-embedded human lymphoma tissue slide using Catalog No:108364(BAX Antibody) at dilution of 1:200 (under 40x lens).

Immunofluorescent analysis of HEK-293 cells using Catalog No:108364(BAX Antibody) at dilution of 1:25 and Alexa Fluor 488-congugated AffiniPure Goat Anti-Rabbit IgG(H+L)

1X10^6 Raji cells were stained with 0.2ug BAX antibody (Catalog No:108364, red) and control antibody (blue). Fixed with 4% PFA blocked with 3% BSA (30 min). Alexa Fluor 488-congugated AffiniPure Goat Anti-Rabbit IgG(H+L) with dilution 1:1500.
-
Background
BAX, also named as BCL2L4, is a pro-apoptotic member of the Bcl-2 protein family, which plays a pivotal role in controlling cell life and death. Bax largely localizes to the cytoplasm of healthy cells, but accumulates on the outer mitochondrial membrane upon apoptosis induction (PMID: 9108035). BAX can commit a cell to apoptosis by translocation from the cytosol to the mitochondria and permeabilization of the outer mitochondrial membrane, which leads to the release of cytochrome c from mitochondria (PMID: 21763611). The expression of BAX is upregulated by the tumor suppressor protein p53, and BAX has been shown to be involved in p53-mediated apoptosis (PMID: 8183579).
-
References
- Mei L, Chen Y, Wang Z. Synergistic anti-tumour effects of tetrandrine and chloroquine combination therapy in human cancer: a potential antagonistic role for p21. British journal of pharmacology. 172(9):2232-45. 2015.
- Zhang XF, Pan QZ, Pan K. Expression and prognostic role of ubiquitination factor E4B in primary hepatocellular carcinoma. Molecular carcinogenesis. 55(1):64-76. 2016.
- Zhang ZS, Yang DY, Fu YB, Zhang L, Zhao QP, Li G. Knockdown of CkrL by shRNA deteriorates hypoxia/reoxygenation-induced H9C2 cardiomyocyte apoptosis and survival inhibition Via Bax and downregulation of P-Erk1/2. Cell biochemistry and function. 33(2):80-8. 2015.
- Xie X, Zhang J, Chen D. Effects of ghrelin on postresuscitation brain injury in a rat model of cardiac arrest. Shock (Augusta, Ga.). 43(5):490-6. 2015.
- Li X, Zou K, Gou J. Effect of baicalin-copper on the induction of apoptosis in human hepatoblastoma cancer HepG2 cells. Medical oncology (Northwood, London, England). 32(3):72. 2015.
- Liu W, Ning R, Chen RN. Aspafilioside B induces G2/M cell cycle arrest and apoptosis by up-regulating H-Ras and N-Ras via ERK and p38 MAPK signaling pathways in human hepatoma HepG2 cells. Molecular carcinogenesis. 2015.
- Shi J, Ren C, Liu H. An ESRG-interacting protein, COXII, is involved in pro-apoptosis of human embryonic stem cells. Biochemical and biophysical research communications. 460(2):130-5. 2015.
- Huang W, Liu J, Feng X. DLC-1 induces mitochondrial apoptosis and epithelial mesenchymal transition arrest in nasopharyngeal carcinoma by targeting EGFR/Akt/NF-κB pathway. Medical oncology (Northwood, London, England). 32(4):115. 2015.
Related Products / Services
Please note: All products are "FOR RESEARCH USE ONLY AND ARE NOT INTENDED FOR DIAGNOSTIC OR THERAPEUTIC USE"
